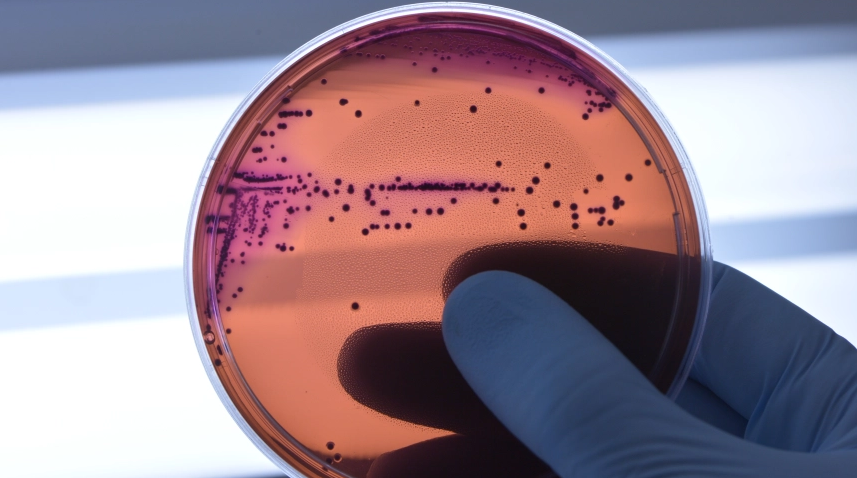

A complexa luta contra os supermicróbios
Por Flávio Dieguez para o Outras Palavras – OMS fecha a Semana de Conscientização Antimicrobiana, em alerta. Num mundo desigual, convivem uso abusivo e escassez de antibióticos. Essas condições favorecem infecções resistentes – e a Big Pharma, de olho nos lucros, não age.
Por Flávio Dieguez para o Outras Palavras –
OMS fecha a Semana de Conscientização Antimicrobiana, em alerta. Num mundo desigual, convivem uso abusivo e escassez de antibióticos. Essas condições favorecem infecções resistentes – e a Big Pharma, de olho nos lucros, não age.
Em um mundo insalubre, onde metade da população não tem sistemas de saúde adequados, o desastre planetário das bactérias está no foco da Organização Mundial de Saúde (OMS) e sua Semana Mundial de Conscientização Antimicrobiana (18 a 24 de novembro). Diversas outras instituições participam dessa mobilização, como a Organização Pan-Americana da Saúde (Opas), que na última sexta (19/11) destacou sua campanha de “conscientização da resistência antimicrobiana” (AMR na sigla inglesa). “Os antibióticos estão perdendo a eficácia”, adverte a médica argentina Pilar Ramon-Pardo, coordenadora da AMR na Opas.
Em vista disso, diz Pilar, a AMR incentiva ações que procuram prevenir o surgimento e a disseminação de infecções resistentes aos antibióticos – portanto, muito difíceis de debelar. As iniciativas de conscientização visam o público em geral, profissionais de saúde e legisladores, e buscam expor os riscos do uso inadequado, em geral excessivo, dos medicamentos. Esse é um lado do problema: o outro, como enfatiza a organização Médicos sem Fronteira (MSF), é a falta de acesso a antibióticos em grande número de países de baixa e de média renda.
Essa situação acelera os problemas combatidos pela AMR e a proliferação de infecções resistentes. Ocorre nesses países uma interseção perversa de sistemas de saúde fracos, com cobertura e financiamento de saúde insuficientes e pouca capacidade para responder à resistência aos fármacos antimicrobianos. Sem falar nos sistemas de água e saneamento ruins, argumentaram os MSF num artigo publicado na revista The Lancet. “A pandemia da covid-19 expôs e ampliou as desigualdades no acesso aos cuidados de saúde em muitos dos países onde trabalhamos”.
No Brasil, por exemplo, a Fiocruz afirma ter estudado três vezes mais amostras de bactérias resistentes a antibióticos, durante a pandemia. Os pesquisadores registraram cerca de mil amostras em 2019, depois quase 2 mil micróbios, em 2020, e em 2021, até outubro, 3,7 mil amostras vindas de diversos estados. Em reforço a seus alertas, os MSF mencionam teses acadêmicas sobre as desigualdades gigantes da Saúde. A pandemia global do coronavírus, para muitos pesquisadores, mostra o fracasso em enfrentar uma emergência global de saúde.
A pandemia carreou gastos públicos em volume sem precedentes, mas deixou outras áreas desamparadas, inclusive ameaças de longa data, como as infecções bacterianas resistentes. Essa é a área mais fraca e a que recebe menos financiamento global, diz um estudo bem atualizado no assunto. Seus autores argumentam que o coronavírus e os supermicróbios são emergências sanitárias paralelas e interativas. A resistência microbianas também se espalha rapidamente em todo o mundo por meio de viagens internacionais, migração e cadeias de suprimentos. O estudo conclui que o acesso a antibióticos eficazes é uma das bases atuais dos sistemas de saúde.
Futuras pandemias virais, alegam, carregam um significativo risco de hospitalização e de muitos casos de infecções bacterianas secundárias. Os sistemas de saúde no mundo todo precisarão de acesso oportuno aos antibióticos. O que justifica o trabalho atual da OMS de monitorar a produção de novos fármacos desse tipo, tentando articular a sua distribuição para as populações de menor renda. No entanto, analisa o estudo mencionado acima, os grandes fabricantes comerciais não consideram lucrativo atender às necessidades globais. Sugere-se, como alternativa, criar ou recorrer a “organizações de pesquisa e desenvolvimento sem fins lucrativos” já existentes. “Com o apoio de financiadores públicos e sem restrições por requisitos de lucratividade comercial”, elas ”poderiam fornecer de forma viável novos antibióticos a todos os necessitados”.
#Envolverde




